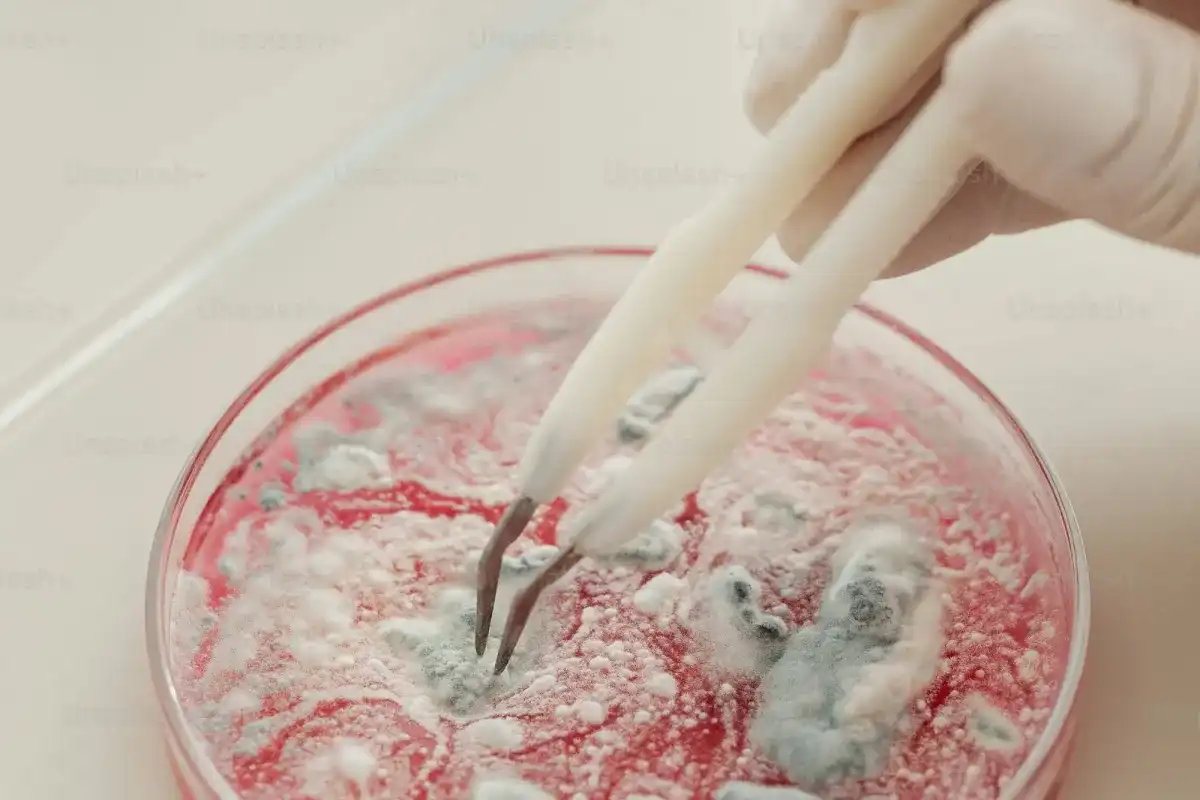

办证所需的条件
服务指南
办理基本流程:
1.农业农村部政务服务大厅农药窗口接收申请人递交的《衣药登记试验单位认定申请书》及其相关材料,并进行形式审查,申请材料不齐全或不符合法定形式的,告知申请人补正;申请材料齐全、符合法定形式的予以受理。
2.农业农村部农药检定所对受理的申请材料进行资料审查。
3.资料审查符合要求的,农业农村部农药管理司组织专家开展现场检查;资料审查不符合要求的,提交综合评审,提出审批意见后按程序报批。
4.农业农村部农药管理司根据资料审查和现场检查结果进行综合评审,提出审批意见后按程序报批。
5.农业农村部农药管理司根据部领导签批文件办理批件、制作《农药登记试验单位证书》。
6.咨询流程图

7.认证流程图

我们所能提供的服务





相关文章

18576401396
18576401396 







